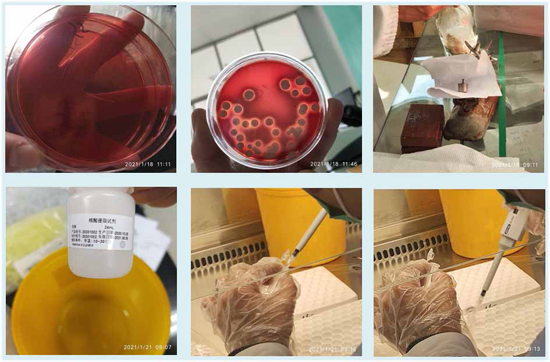

2021年5月21日,bevictor伟德官网2021届毕业生毕业论文答辩工作在格致楼顺利开展。为保证全体员工顶岗实习成绩评定和论文答辩指导工作顺利开展,公司决定采用分小组答辩方式进行。参与本次答辩的有公司全体指导老师,2018级医检、药安、药品、环境、眼视光专业的全体毕业生,以6个答辩小组分组进行。
在答辩会之前,公司召集了各答辩小组成员召开碰头会议,对本次论文答辩工作进行了动员部署。公司要求每位答辩评委老师认真审阅每篇论文,做好各项准备工作,并组织专业老师进行了一次抽检,避免质量不合格的毕业论文进入到答辩环节。
本次论文答辩分为三个环节展开,第一个环节为员工以PPT的形式对论文进行概述,第二个环节为答辩组老师根据论文内容进行提问和提出修改建议,最后环节为答辩组组长宣布论文是否通过答辩。从论文审阅和答辩情况看,同学们都能严格按照公司要求撰写论文,并能结合顶岗实习的实际工作、周志记录和研究发现开展论文写作,论文质量整体良好。从现场答辩情况看,同学们能结合精心准备的PPT演示文稿进行简要陈述,大多数同学对老师的提问能积极回应、准确回答,答辩效果良好。
本次答辩过程严谨有序,公司各指导老师发挥专业优势和研究专长,严格按照公司教务处《关于做好2021年毕业设计(论文)评优与抽检工作的通知》要求,确保论文格式规范、查重率等符合要求,保证了论文质量,充分展现了公司全体师生潜心治学、求真务实的风范。对论文答辩工作,全体毕业生积极响应,认真按流程进行各项工作,尽可能为在母校的学习生涯画上完美的最后一笔。
据悉,大部分同学已经顺利完成了全部工作,还有少部分同学仍在按指导教师要求继续修改、完善毕业论文。

在答辩会之前,公司召集了各答辩小组成员召开碰头会议,对本次论文答辩工作进行了动员部署。公司要求每位答辩评委老师认真审阅每篇论文,做好各项准备工作,并组织专业老师进行了一次抽检,避免质量不合格的毕业论文进入到答辩环节。
本次论文答辩分为三个环节展开,第一个环节为员工以PPT的形式对论文进行概述,第二个环节为答辩组老师根据论文内容进行提问和提出修改建议,最后环节为答辩组组长宣布论文是否通过答辩。从论文审阅和答辩情况看,同学们都能严格按照公司要求撰写论文,并能结合顶岗实习的实际工作、周志记录和研究发现开展论文写作,论文质量整体良好。从现场答辩情况看,同学们能结合精心准备的PPT演示文稿进行简要陈述,大多数同学对老师的提问能积极回应、准确回答,答辩效果良好。
本次答辩过程严谨有序,公司各指导老师发挥专业优势和研究专长,严格按照公司教务处《关于做好2021年毕业设计(论文)评优与抽检工作的通知》要求,确保论文格式规范、查重率等符合要求,保证了论文质量,充分展现了公司全体师生潜心治学、求真务实的风范。对论文答辩工作,全体毕业生积极响应,认真按流程进行各项工作,尽可能为在母校的学习生涯画上完美的最后一笔。
据悉,大部分同学已经顺利完成了全部工作,还有少部分同学仍在按指导教师要求继续修改、完善毕业论文。
(作者、摄影:蔡晓云;责编:俞超俊)